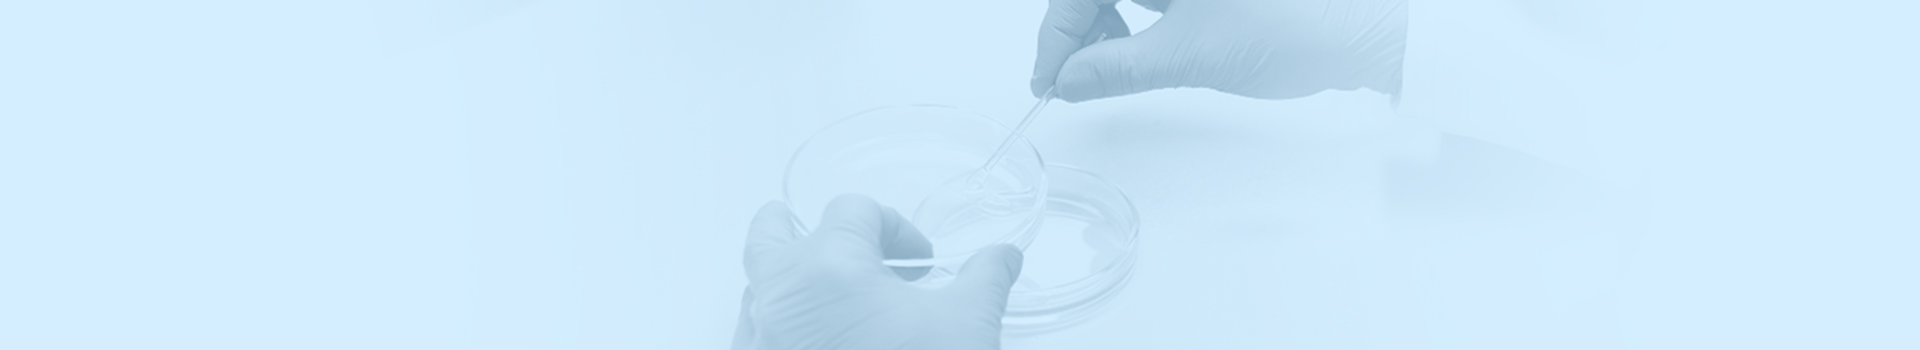

Merkezi Biyokimya ve Mikrobiyoloji Laboratuvarı
Tıbbi Birimler

Tıbbi Birimler
Klinik biyokimya laboratuvarı; kan, serum, idrar gibi vücut sıvılarında biyokimyasal parametrelerin analizi yoluyla teşhis ve tedaviyi yönlendirirken; doğru, güvenilir ve hızlı test sonuçlarının teminini sağlama yönünde çalışmaktadır. Bu bölümde, bakteri, mantar kültür tanımlama işlemleri, antimikrobiyal ve antifungal duyarlılık testleri ile doğrulama ve moleküler testler alanında uzman tıbbi laboratuvar teknikerleri tarafından, modern lab cihazları yardımı ile gerçekleştirilmektedir.
Tıbbi laboratuvar bilimleri alanında, mikoloji, parazitoloji, seroloji, moleküler, immunfloresan mikroskopi ve deri sınıflandırmasına dâhil olan yukarıdaki testlerin gerçekleştirilmesi ile özellikle enfeksiyona bağlı hastalıklar en doğru biçimde teşhis edilebilirken, tedavi seçenekleri de güvenli bir şekilde gözden geçirilir; tedavi sonrası hastanın ne derece yarar gördüğü yine uluslararası standartlarda tamamlanan bu testler aracılığıyla saptanır.
Esencan Hastanesi merkezi biyokimya ve mikrobiyoloji laboratuvarında, tıbbi test analizi yapma konusunda ihtisasını tamamlamış olan nitelikli laborantlar, hastane bünyesinde çalışmakta olan hekimler ve diğer sağlık çalışanları ile ortak hareket ederek, günde binlerce testin, yüzlerce test parametresinden geçerek tamamlanmasını sağlar.
Çağdaş laboratuvarlar kategorisinde yer alan merkezi biyokimya ve mikrobiyoloji departmanında ayrıca, başta Amerika Birleşik Devletleri ve İngiltere olmak üzere birçok gelişmiş ülkede kullanılan klinik laboratuvar standartları benimsenmiştir. Buna göre, örnek materyalin en hızlı, aynı zamanda da en uygun koşullar dâhilinde laboratuvara ulaştırılmasına çalışılırken, iç ve dış kalite kontrol sistemleriyle, periyodik kalibrasyon çalışmalarıyla test sonuçlarının doğruluğu ve güvenirliği temin edilmektedir.
İdrar yolu enfeksiyonundan, sarılığa; menenjitten, insanda hastalık yapan HIV (İnsan Bağışıklık Yetmezliği Virüsü) virüslerin neden olduğu AIDS (Kazanılmış Bağışıklık Yetersizliği Sendromu) gibi ciddi rahatsızlıklara kadar pek çok hastalığın teşhis edilmesine olanak sağlayan tahlillerin gerçekleştirildiği Esencan Hastanesi merkezi biyokimya ve mikrobiyoloji laboratuvarı son dönem test tekniklerin kullanılabilmesi adına, modern ekipmanlar, identifikasyon ve duyarlılık cihazlarla donatılmıştır.
Daha hızlı bir biçimde, doğru ve güvenli teşhis ve tedavilerin yapılması için Esencan merkezi biyokimya ve mikrobiyoloji laboratuvarı 365 gün 24 saat, nitelikli teknik ve idari personeli ile hizmet vermektedir.
Esencan Hastanesi merkezi biyokimya ve mikrobiyoloji laboratuvarında, mikoloji, parazitoloji, seroloji, moleküler, immunfloresan mikroskopi ve deri grupları dâhilinde aşağıdaki testler gerçekleştirilmektedir:
Özel Esencan Hastanesi olarak bölüm doktorlarımız.
Tamamını Görüntüle
Özel Esencan Hastanesi olarak hizmet verdiğimiz branşlar.

Bulaşıcı ve kronik hastalıkların tanı, tedavi ve takip hizmetlerini sunan birimdir.
Tamamını Görüntüle
Ruhsal bozuklukların tanı, tedavi ve yaşam kalitesini artırmaya yönelik psikolojik destek sunan bir alandır.
Tamamını Görüntüle
Kulak, burun, boğaz ve boyun bölgesine ait hastalıkların tanı ve tedavisini gerçekleştiren birimdir.
Tamamını Görüntüle
Botox, PRP ve benzeri yöntemlerle estetik görünüm ve medikal tedavi sağlayan merkezdir.
Tamamını Görüntüle

